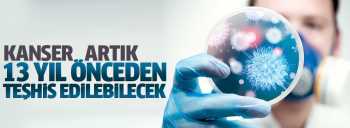
ÖLÜMCÜL HASTALIK 13 YIL ÖNCEDEN TESPİT EDİLEBİLECEK

Çorum FK – Sivasspor maçı
Yeşilay’dan Hitit TV Net’e Ziyaret!
"Çorum’da Provokatif Paylaşımlara Gözaltı!
Kırkdilim Tünelleri Trafiğe Açıldı!
Çorum-Samsun Hızlı Tren Hattı Resmileşti "Acele ka…
YEDAŞ’tan - Çorum’a 9 Milyar TL’lik Dev Enerji Yat…
"Çorum’da Araç Sayısı 227 Bini Geçti! Her 2 Kişiye…
Okullarda ve Çevresinde Alınacak Güvenlik Önlemler…
Dr. Süleyman Basa’dan "Sosyal Medya Düzenlemesine …
WHATSAPP’ta Okul Saldırısı Paylaşımı Paniğe Neden …
Çorum’a Dev Proje / Teras Bahçe Geliyor!
Çorum’da İUP Kapsamında 200 Kişiye İş Fırsatı!
Hasan Karaoğlu Çorum Protokolüne Valilik Oluruyla …
Kahramanmaraş’ta Okula Silahlı Saldırı 4 Kişi Öldü…
Çorum’da Öğretmen Sendikalarından İş Bırakma Eylem…
"Çimento Arazisindeki Arsalar 21 Nisan’da Satışa Ç…
“Çorum Dahil 12 İlde Doktorlara FETÖ Operasyonu!
Çorum - Kırkdilim Tünelleri Açılışa Hazır!
Hitit TV Net ve Çorum İl Sağlık Müdürlüğü "Sorumlu…
Çorum’da bıçaklı kavgada 2 genç yaralandı,1 kişi g…
Çorum nüfusuna kayıtlı baba ve oğlu sobadan zehir…
Hukukçular Derneği'nden İsrail'e Tepki "Bu Yasa Sa…
Ahlatcı Holding’den HALK Bank Genel Müdürlüğü’ne a…
Altın Rafinerileri Derneği Kuruldu!
Rosse Garden Çorum’da Hizmete Açıldı!!



Aradığınız Kelime: Hasta
-
 O Gün Beni Darp Edenlere Susanlara Hakkımı Helal Etmiyorum
Elvan Simsek
O Gün Beni Darp Edenlere Susanlara Hakkımı Helal Etmiyorum
Elvan Simsek
-
 Cumhurbaşkanı Bir milletin Onurudur Namusudur!
Elvan Simsek
Cumhurbaşkanı Bir milletin Onurudur Namusudur!
Elvan Simsek
-
 Kâbus bitti
Ahmet Kekeç
Kâbus bitti
Ahmet Kekeç
-
 Berat Albayrak Neden Hedef?
Ersoy Dede
Berat Albayrak Neden Hedef?
Ersoy Dede
-
 Gökten Ağır Zehirden Acı!
Yüsra D.Büyükcebeci
Gökten Ağır Zehirden Acı!
Yüsra D.Büyükcebeci
-
 Bir CHP’linin itirafları: Kaybettiğimiz seçimdir
Sabiha Doğan
Bir CHP’linin itirafları: Kaybettiğimiz seçimdir
Sabiha Doğan
-
 Hoşlansanız da olacak, hoşlanmasanız da olacak!
Ahmet Kekeç
Hoşlansanız da olacak, hoşlanmasanız da olacak!
Ahmet Kekeç
-
 ÇORUM DÜNYA'CA ÜNLÜ BİR ŞEHİR
Prf. Dr. İlknur TAŞ
ÇORUM DÜNYA'CA ÜNLÜ BİR ŞEHİR
Prf. Dr. İlknur TAŞ
-
 DÜNYA’DA TÜRK HEKİMLERİ VE BAŞARI ÖYKÜLERİ
Esra Öz
DÜNYA’DA TÜRK HEKİMLERİ VE BAŞARI ÖYKÜLERİ
Esra Öz
-
 Çorum FK – Sivasspor maçı
Çorum FK – Sivasspor maçı
-
 Yaşar Sol Hayatını Kaybetti!..
Yaşar Sol Hayatını Kaybetti!..
-
 Yeşilay’dan Hitit TV Net’e Ziyaret!
Yeşilay’dan Hitit TV Net’e Ziyaret!
-
 "Çorum’da Provokatif Paylaşımlara G…
"Çorum’da Provokatif Paylaşımlara G…
-
 Kırkdilim Tünelleri Trafiğe Açıldı!
Kırkdilim Tünelleri Trafiğe Açıldı!
-
 Çorum-Samsun Hızlı Tren Hattı Resmi…
Çorum-Samsun Hızlı Tren Hattı Resmi…
-

-
 "Çorum’da Araç Sayısı 227 Bini Geçt…
"Çorum’da Araç Sayısı 227 Bini Geçt…
-
 Okullarda ve Çevresinde Alınacak Gü…
Okullarda ve Çevresinde Alınacak Gü…
-
 Dr. Süleyman Basa’dan "Sosyal Medya…
Dr. Süleyman Basa’dan "Sosyal Medya…
-
 WHATSAPP’ta Okul Saldırısı Paylaşım…
WHATSAPP’ta Okul Saldırısı Paylaşım…
-
 Çorum’a Dev Proje / Teras Bahçe Ge…
Çorum’a Dev Proje / Teras Bahçe Ge…
-
 Çorum’da İUP Kapsamında 200 Kişiye…
Çorum’da İUP Kapsamında 200 Kişiye…
-
 Hasan Karaoğlu Çorum Protokolüne Va…
Hasan Karaoğlu Çorum Protokolüne Va…
-
 Kahramanmaraş’ta Okula Silahlı Sald…
Kahramanmaraş’ta Okula Silahlı Sald…
-
 Çorum’da Öğretmen Sendikalarından İ…
Çorum’da Öğretmen Sendikalarından İ…
-
 "Çimento Arazisindeki Arsalar 21 Ni…
"Çimento Arazisindeki Arsalar 21 Ni…
-
 “Çorum Dahil 12 İlde Doktorlara FET…
“Çorum Dahil 12 İlde Doktorlara FET…
-
 Çorum - Kırkdilim Tünelleri Açılışa…
Çorum - Kırkdilim Tünelleri Açılışa…
-
 Hitit TV Net ve Çorum İl Sağlık Müd…
Hitit TV Net ve Çorum İl Sağlık Müd…
 SON DAKİKA
SON DAKİKA
-
14:27
Çorum FK – Sivasspor maçı
-
21:18
Yeşilay’dan Hitit TV Net’e Ziyaret!
-
17:24
"Çorum’da Provokatif Paylaşımlara Gözaltı!
-
15:12
Kırkdilim Tünelleri Trafiğe Açıldı!
-
12:23
Çorum-Samsun Hızlı Tren Hattı Resmileşti "Acele kamulaştırma kararı yayımlandı!
-
10:59
-
17:47
"Çorum’da Araç Sayısı 227 Bini Geçti! Her 2 Kişiye 1 Araç Düşüyor!
-
15:19
Okullarda ve Çevresinde Alınacak Güvenlik Önlemleri İçin Kritik Toplantı!
-
10:55
Dr. Süleyman Basa’dan "Sosyal Medya Düzenlemesine Destek!
-
10:29
WHATSAPP’ta Okul Saldırısı Paylaşımı Paniğe Neden Oldu!
-
07:44
Çorum’a Dev Proje / Teras Bahçe Geliyor!
-
16:37
Çorum’da İUP Kapsamında 200 Kişiye İş Fırsatı!
-
16:23
Hasan Karaoğlu Çorum Protokolüne Valilik Oluruyla Dahil Edildi
-
15:35
Kahramanmaraş’ta Okula Silahlı Saldırı 4 Kişi Öldü 20 Kişi Yaralandı!
-
08:25
Çorum’da Öğretmen Sendikalarından İş Bırakma Eylemi!
-
22:51
"Çimento Arazisindeki Arsalar 21 Nisan’da Satışa Çıkıyor!
-
22:33
“Çorum Dahil 12 İlde Doktorlara FETÖ Operasyonu!
-
10:46
Çorum - Kırkdilim Tünelleri Açılışa Hazır!
-
15:09
Hitit TV Net ve Çorum İl Sağlık Müdürlüğü "Sorumlu Yayıncılıkta Ortak Duruş” Sergiledi!
-
14:03
Çorum’da bıçaklı kavgada 2 genç yaralandı,1 kişi gözaltında!
-
12:49
Çorum nüfusuna kayıtlı baba ve oğlu sobadan zehirlendi!
-
11:55
Hukukçular Derneği'nden İsrail'e Tepki "Bu Yasa Savaş Suçudur"
-
23:58
Ahlatcı Holding’den HALK Bank Genel Müdürlüğü’ne atanan Osman Arslan’a kutlama mesajı
-
16:25
Altın Rafinerileri Derneği Kuruldu!
-
10:57
Rosse Garden Çorum’da Hizmete Açıldı!!
 HAVA DURUMU
HAVA DURUMU
 ANKET
ANKET
- http://www.hitittv.net Çorum'un Ulusal ve Yerel
- İnteraktif haber sitesi
- Sondakika Çorum Haberleri

O Gün Beni Darp Edenlere Susanlara Hakkımı Helal Etmiyorum
O Gün Beni Darp Edenlere Susanlara Hakkımı Helal Etmiyorum
 Cumhurbaşkanı Bir milletin Onurudur Namusudur!
Cumhurbaşkanı Bir milletin Onurudur Namusudur!
 Kâbus bitti
Kâbus bitti
 Berat Albayrak Neden Hedef?
Berat Albayrak Neden Hedef?
 Gökten Ağır Zehirden Acı!
Gökten Ağır Zehirden Acı!
 Bir CHP’linin itirafları: Kaybettiğimiz seçimdir
Bir CHP’linin itirafları: Kaybettiğimiz seçimdir
 ÇORUM DÜNYA'CA ÜNLÜ BİR ŞEHİR
ÇORUM DÜNYA'CA ÜNLÜ BİR ŞEHİR
 DÜNYA’DA TÜRK HEKİMLERİ VE BAŞARI ÖYKÜLERİ
DÜNYA’DA TÜRK HEKİMLERİ VE BAŞARI ÖYKÜLERİ
 Çorum FK – Sivasspor maçı
Çorum FK – Sivasspor maçı
 Yaşar Sol Hayatını Kaybetti!..
Yaşar Sol Hayatını Kaybetti!..
 Yeşilay’dan Hitit TV Net’e Ziyaret!
Yeşilay’dan Hitit TV Net’e Ziyaret!
 "Çorum’da Provokatif Paylaşımlara G…
"Çorum’da Provokatif Paylaşımlara G…
 Kırkdilim Tünelleri Trafiğe Açıldı!
Kırkdilim Tünelleri Trafiğe Açıldı!
 Çorum-Samsun Hızlı Tren Hattı Resmi…
Çorum-Samsun Hızlı Tren Hattı Resmi…

 "Çorum’da Araç Sayısı 227 Bini Geçt…
"Çorum’da Araç Sayısı 227 Bini Geçt…
 Okullarda ve Çevresinde Alınacak Gü…
Okullarda ve Çevresinde Alınacak Gü…
 Dr. Süleyman Basa’dan "Sosyal Medya…
Dr. Süleyman Basa’dan "Sosyal Medya…
 WHATSAPP’ta Okul Saldırısı Paylaşım…
WHATSAPP’ta Okul Saldırısı Paylaşım…
 Çorum’a Dev Proje / Teras Bahçe Ge…
Çorum’a Dev Proje / Teras Bahçe Ge…
 Çorum’da İUP Kapsamında 200 Kişiye…
Çorum’da İUP Kapsamında 200 Kişiye…
 Hasan Karaoğlu Çorum Protokolüne Va…
Hasan Karaoğlu Çorum Protokolüne Va…
 Kahramanmaraş’ta Okula Silahlı Sald…
Kahramanmaraş’ta Okula Silahlı Sald…
 Çorum’da Öğretmen Sendikalarından İ…
Çorum’da Öğretmen Sendikalarından İ…
 "Çimento Arazisindeki Arsalar 21 Ni…
"Çimento Arazisindeki Arsalar 21 Ni…
 “Çorum Dahil 12 İlde Doktorlara FET…
“Çorum Dahil 12 İlde Doktorlara FET…
 Çorum - Kırkdilim Tünelleri Açılışa…
Çorum - Kırkdilim Tünelleri Açılışa…
 Hitit TV Net ve Çorum İl Sağlık Müd…
Hitit TV Net ve Çorum İl Sağlık Müd…












